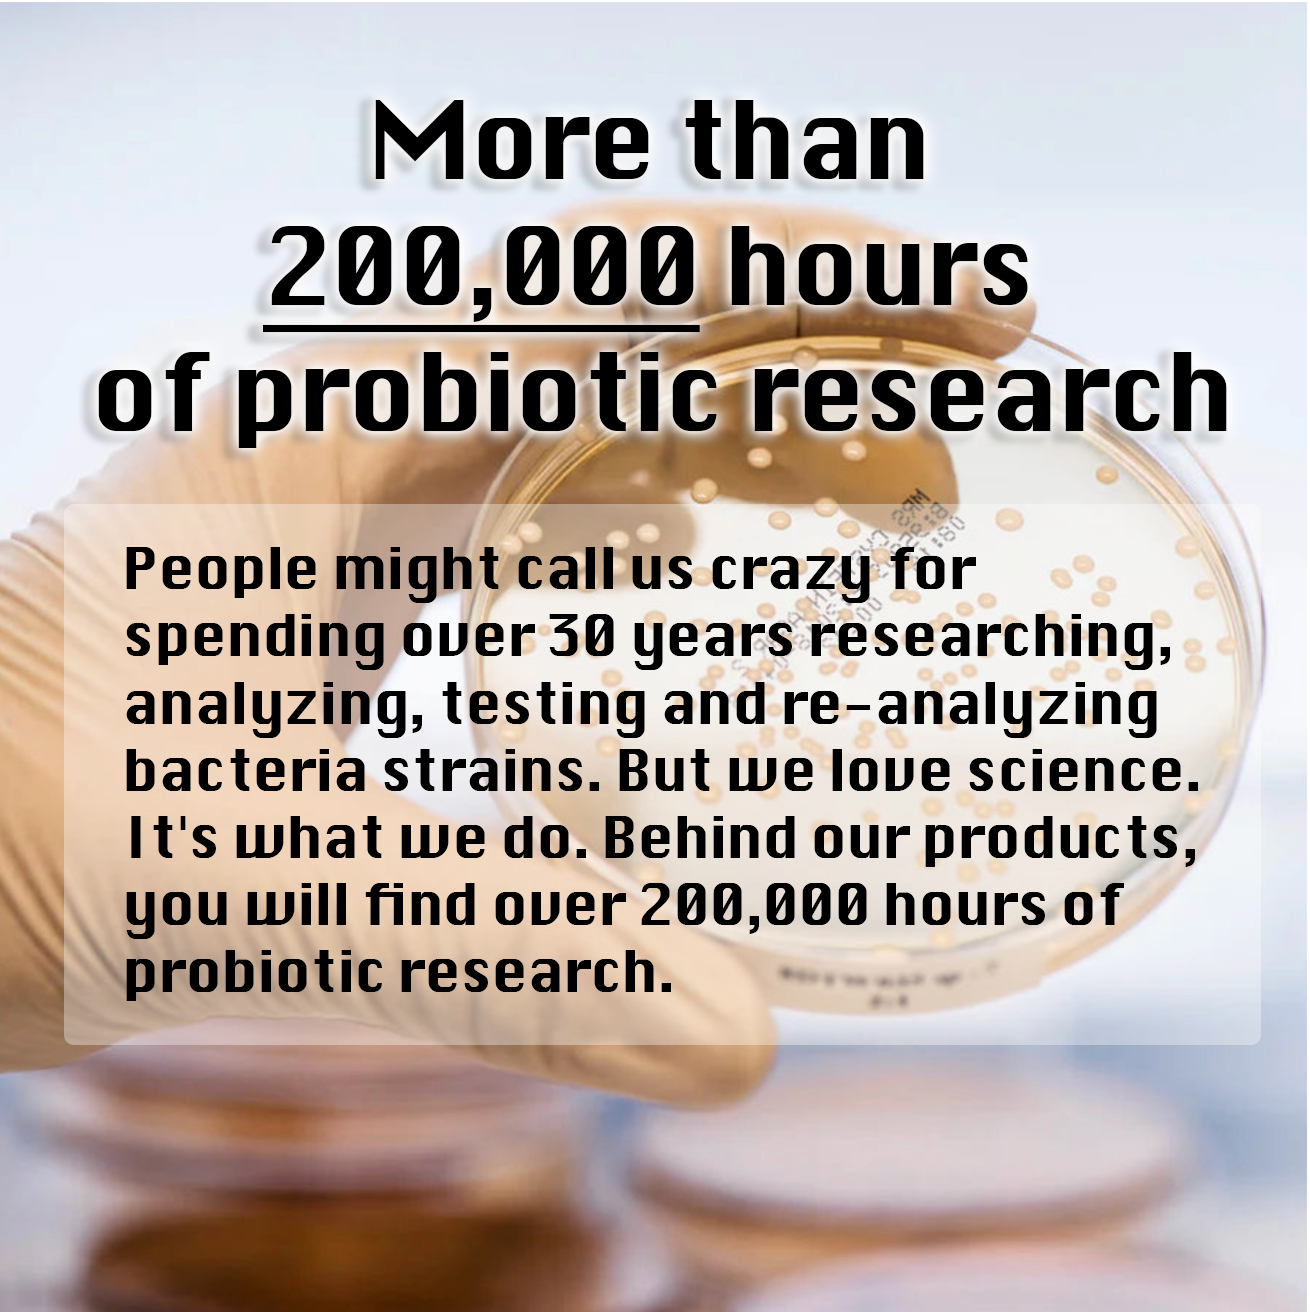

BioGaia® Aldermis® Baby Probiotic Ointment (23g)
BioGaia® Aldermis® Baby Probiotic Ointment (23g)
STEP 1: Choose the Bulk Discount Tier (If any)
Step 2: Increase the quantity you need
Couldn't load pickup availability
SUITABLE FROM BIRTH
INDICATIVE BEST BEFORE: 06-2026
BioGaia® Aldermis® Baby Probiotic Ointment is an emollient ointment with a base of anhydrous shea butter and contains the patented probiotic strain Limosilactobacillus reuteri DSM 17938. The product is formulated with natural ingredients. Clinically tested probiotic ointment that soothes and moisturizes. The ointment is specially adapted for infants and children, and has been developed with sensitive skin in mind - it is therefore microbiome-friendly, hypoallergenic and completely free of perfume.
- Soothes dry, irritated skin
- Dermatologically tested, non-sensitising & hypoallergenic
- No chemicals
Suggested use
Apply anywhere your baby has dry or sensitive skin. Use twice daily. Avoid contact with eyes. For external use only.
Ingredients
Butyrospermum parkii (shea) butter, canola oil, hydrogenated vegetable oil and Limosilactobacillus reuteri
Share